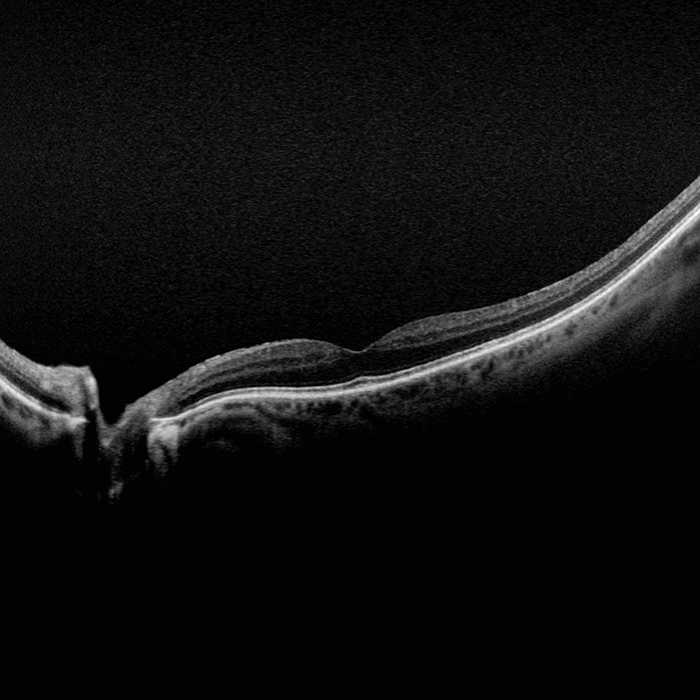

Optos Products
Optos introduced ultra-widefield (UWF™) retinal imaging to enable eyecare professionals to discover, diagnose, document and treat ocular pathology that may first present in the periphery - pathology which may go undetected using traditional examination techniques and equipment. Our UWF, high-resolution retinal imaging devices each image more than 80% or 200˚ of the retina in a single shot. Our complete list of ultra-widefield retinal imaging devices is below.
Below is a complete list of our UWF retinal imaging products.
To determine which device will work best for you, please select filters that most closely describe image modality, patient demographics, and practice focus.
Silverstone
Silverstone, the most powerful tool yet for examining the retina, is the only ultra-widefield imaging device with integrated Swept Source OCT. Silverstone produces a 200° single shot retinal image of unrivaled clarity in less than ½ second and enables optomap guided SS-OCT scanning across the retina and into the far periphery.

Image Modalities
Why Silverstone?
optomap has been shown to enhance pathology detection and disease management and to improve clinic flow. Now with integrated Swept Source OCT, Silverstone facilitates examination of the retina from vitreous through the choroidal-scleral interface.
Silverstone imaging modalities and image viewing options:
optomap Image Modalities
- color rg
- Sensory Retina
- Choroidal
- green af
- fa
- icg
- SS-OCT
Image Views
- Standard: 200⁰ Single Shot
- Auto-montage: Up to 220⁰ (not available for fa or icg)
- Central Pole: Detailed view of the macula
- Stereo: Image pairing for optic disc and retinal evaluation
- OCT: Up to 23mm line scan and swept-source functionality
MonacoPro
MonacoPro takes the proven Optos technology further by integrating cutting-edge MonacoPro SD-OCT image quality into every exam. Engineered for efficiency, MonacoPro captures up to five imaging modalities for both eyes in just 90 seconds, optimizing workflow, streamlining diagnostics, and delivering superior patient care.

Image Modalities
Why MonacoPro?
The MonacoPro captures up to five imaging modalities for both eyes in just 90 seconds, optimizing workflow, streamlining diagnostics, and delivering superior patient care.
MonacoPro imaging modalities and image viewing options:
optomap Image Modalities
- color rg
- Sensory Retina
- Choroidal
- green af
- SD-OCT
Image Views
- Standard: 200⁰ Single Shot
- Auto-montage: Up to 220⁰
- Central Pole: Detailed view of the macula
- Stereo: Image pairing for optic disc and retinal evaluation
- OCT: Cross-sectional imaging of ocular structures, including the fundus
California
California was developed for medical imaging and is a standard for retinal screening programs. California is available in multiple models with multiple imaging modality options. California produces a 200°, single shot retinal image of unrivaled clarity in less than ½ second and is changing the management of diseases including Geographic Atrophy, Diabetic Retinopathy, AMD, and Uveitis.

Image Modalities
Why California?
California was developed to facilitate comprehensive eye exams, document findings, and assist eyecare professionals in disease management and treatment. California is available in various device configurations and image modality options for the flexibility to meet the needs and budget of every eyecare practice. Imaging modalities and viewing options are detailed below.
optomap Image Modalities
- color rgb (available with rg,af,fa combined model)
- color rg
- Sensory Retina
- Choroidal
- green af
- blue af
- fa
- icg
Image Views
- Standard: 200⁰ Single Shot
- Auto-montage: Up to 220⁰ (not available for fa or icg)
- Central Pole: Detailed view of the macula
- Stereo: Image pairing for optic disc and retinal evaluation
- 4-in-1 Color Depth Imaging
Daytona
Daytona produces a 200° single shot optomap retinal image of unrivaled clarity in less than ½ second. This fast, easy, patient-friendly, ultra-widefield imaging technology was designed for healthy eye screening and has been shown to improve practice flow and patient engagement.

Image Modalities
Why Daytona?
optomap has been shown to enhance pathology detection and disease management and to improve clinic flow. The Daytona system is the most widely used true UWF imaging device.
optomap Image Modalities
- color rg
- Sensory Retina
- Choroidal
- green af
Image Views
- Standard: 200⁰ Single Shot
- Auto-montage: Up to 220⁰
- Central Pole: Detailed view of the macula
- Stereo: Image pairing for optic disc and retinal evaluation
Image Modalities